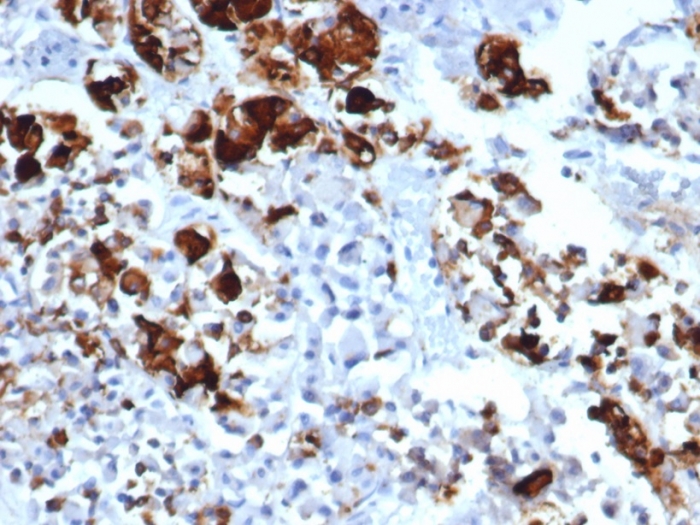

Formalin-fixed, paraffin-embedded human pituitary stained with Prolactin Recombinant Mouse Monoclonal Antibody (rPRL/4909).
Prolactin is a growth factor that is secreted by the anterior pituitary. It is necessary for the proliferation and differentiation of the mammary glands. Prolactin is useful in the classification of pituitary tumors and study of pituitary disease. It also plays a role in the development of mammary cancer, functioning dually as a mitogen and a differentiating agent.
There are no reviews yet.